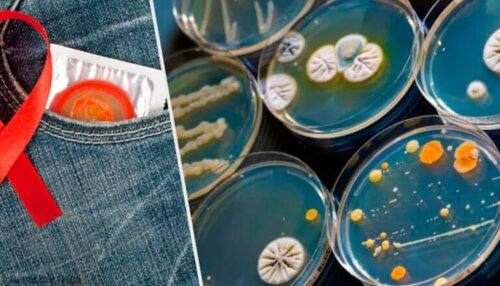
11 seksuelt overførbare sykdommer du trenger å kjenne til

Helse og seksualitet
Seksualitet handler om mye mer enn bare nydelse: det finnes også retningslinjer om beskyttelse og forebygging som du bør kjenne til. I denne seksjonen snakker vi om dysfunksjon, kjønnssykdommer og hva du kan gjøre for å nyte sex på alle tre nivåer: fysisk, mentalt og følelsesmessig.